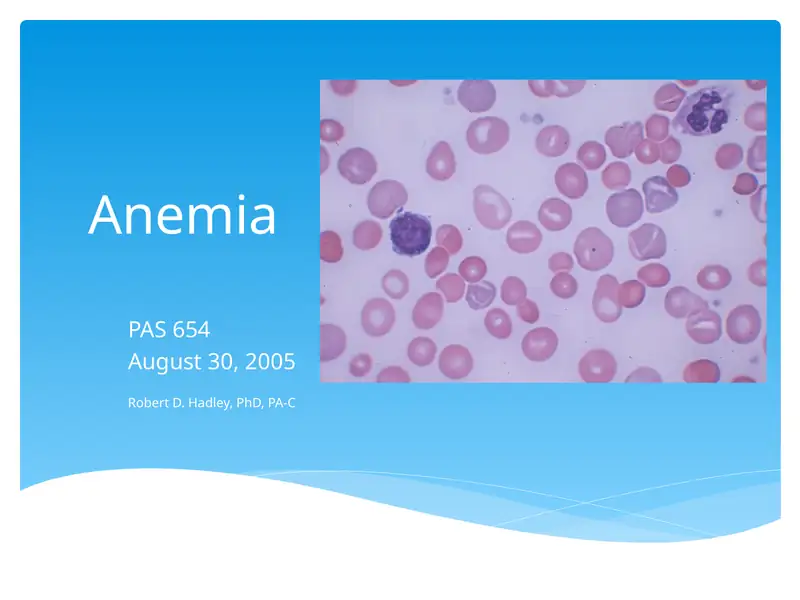
Preview 1

9
Premium Content
Anemia
4,000so'm
Betlar soni
35 taFayl hajmi
1.93 MBFayl turi
.pptMahsulot tavsifi
Anemia is a condition characterized by low levels of red blood cells or hemoglobin in the blood.
Teglar
#hemoglobin#laboratory diagnosis#mcv#wbc#rbc count
Premium Content
Anemia
4,000so'm
Betlar soni
35 taFayl hajmi
1.93 MBFayl turi
.ppt
✓
Muallif
Seller 2
Tasdiqlangan sotuvchi
Jami mahsulotlar1948 ta
Sotilgan121 ta